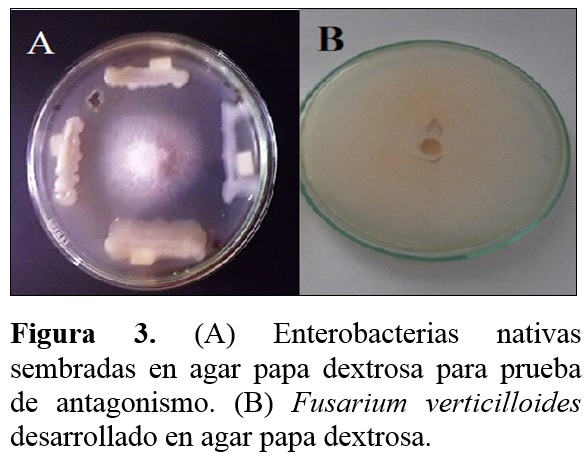

Servicios Personalizados
Revista
Articulo
Indicadores
-
 Citado por SciELO
Citado por SciELO
Links relacionados
-
 Similares en
SciELO
Similares en
SciELO
Compartir
Scientia Agropecuaria
versión impresa ISSN 2077-9917
Scientia Agropecuaria vol.6 no.4 Trujillo oct. 2015
http://dx.doi.org/10.17268/sci.agropecu.2015.04.02
ARTÍCULOS ORIGINALES
Determinación del potencial promotor del crecimiento vegetal de Azotobacter spp. aislados de la rizósfera de malezas en cultivos de maíz (Zea mays L.)
Determination of plant growth promoting potential of Azotobacter spp. isolated from the rhizosphere of weeds in maize crop (Zea mays L.)
Luis H. León*; Luis M. Rojas
Facultad de Ciencias Biológicas, Universidad Nacional Pedro Ruiz Gallo, Av. Juan XXIII 391, Lambayeque, Perú.
Resumen
Los fertilizantes químicos representan entre 20% y 30% de los costos de producción de un cultivo, utilizados correctamente incrementan la productividad y rentabilidad; sin embargo, cada año aumenta la cantidad de fertilizantes por aplicar, debido a la deficiencia de adsorción en el suelo y absorción por la planta. Siendo el maíz el tercer cultivo de importancia en Perú, con un impacto significativo en la actividad económica y social, en el 2014, solo el 40% del maíz ofertado correspondió a la producción nacional. En busca de alternativas para disminuir el uso de fertilizantes químicos se realizan investigaciones con denominadas rizobacterias promotoras del crecimiento vegetal (PGPR, por sus siglas en ingles). Se identificaron 37 malezas en cultivos de maíz procedentes de campos agrícolas de los distritos de Monsefú y Reque, Región Lambayeque, siendo dicotiledóneas predominantes con 68 % con respecto a monocotiledóneas con 32%. Las bacterias se aislaron de la rizósfera de malezas, obteniendo 305 cultivos puros de bacterias, de los cuales 133 cultivos puros (43,7%) se identificaron como Azotobacter spp., investigándose su reacción bioquímica en reducción de nitratos, utilización de sacarosa, glucosa, maltosa, manitol, ramnosa, glicerol y sorbitol, identificándose A. vinelandii (58%), A. paspali (13%), A. armeniacus (8%), A. nigricans (8%) y en 13 cultivos no se identificó la especie. Con los cultivos Azotobacter spp. se cuantificó hasta 36,03 ppm de nitrógeno fijado como amonio; 60,75 ppm de ácido indol acético y 6,06 ppm de fósforo solubilizado, se determinó actividad antagónica contra Fusarium verticillioides, proteolítica y quitinolítica y. El 20% de Azotobacter spp. no afectó la emergencia de maíz amarillo duro hibrido simple AGRI- 144, el 33 % la afectó positivamente y el 47% la afectó negativamente. A su vez, ningún Azotobacter spp. afectó la sobrevivencia. Demostrándose el potencial promotor del crecimiento vegetal de Azotobacter spp. aislados de malezas en cultivos de maíz en la Región de Lambayeque.
Palabras clave: Maíz, malezas, Azotobacter spp, PGPR, Lambayeque.
Abstract
The chemical fertilizer represents for 20 and 30 % of cost the production a crop, used correctly increase productivity and profitability, however, each year increase the among of fertilizer to apply, due to deficiency of soil adsorption and absorption by the plant. Beging maize the third most important crop in Peru, with a significant impact on economic and social activity in 2014, only 40% of the offered maize corresponded of the production nacional. 37 weeds were identified associated with crops of maize from agricultural fields Monsefú districts and Reque, Lambayeque Region, with 68% being dicotyledonous against monocots with 32%. Bacteria were isolated from the rhizosphere of weeds, getting 305 pure cultures of bacteria, 133 of which (43.7%) were identified as Azotobacter spp. Investigated the biochemical reaction in nitrate reduction, utilization of sucrose, glucose, maltose, mannitol, rhamnose, glycerol and sorbitol. Identifying A. vinelandii (58%), A. paspali (13%), A. armeniacus (8%), A. nigricans (8%) and 13 cultives not the species was identified. With this cultives pure of Azotobacter spp. native was quantified to 36.03 ppm of fixed nitrogen as ammonia; 60.75 ppm of indole acetic acid and 6.06 ppm solubilized phosphorus was also determined the activity antagonistic to Fusarium verticillioides, proteolytic and chitinolytic. 20% of Azotobacter spp. native did not affect the emergence of simple hybrid hard yellow corn 144 agriculture, 33% positively affected and 47% negatively affected. In turn, none Azotobacter spp. affect negatively survival. The potential of the plant growth promoter of Azotobacter spp. isolated from weeds in maize crops in the region of Lambayeque been demonstrated.
Keywords: Maize, weeds, Azotobacter spp, PGPR, Lambayeque.
1. Introducción
En el Perú el maíz amarillo duro es uno de los cultivos más importantes. Se siembra mayoritariamente en la costa y selva, siendo Lambayeque, La Libertad, Ancash, Lima y San Martin los principales productores, que en conjunto representan el 55 % del área cultivada (Injante y Joyo, 2010). Los fertilizantes químicos son concentrados y tienen buena solubilidad en agua, no obstante, hasta el 70 % de algunos fertilizantes como los nitrogenados por su solubilidad y carga negativa se pierden por lixiviación, desnitrificación, volatilización y erosión, disminuyendo su efectividad, bajo una agricultura intensiva, en general los fertilizantes químicos degradan el suelo, debido a la pérdida de materia orgánica y de cationes, causando acidificación del suelo y desbalance de nutrientes. Esta acidez en presencia de iones tóxicos origina liberación de aluminio, manganeso y otros metales pesados, con deficiencia de magnesio y calcio, disminución de la disponibilidad de fósforo, así como del número y actividad de los microorganismos (Salhia, 2010). En la búsqueda de alternativas para disminuir el uso de fertilizantes químicos se realizan investigaciones con las denominadas rizobacterias promotoras del crecimiento de las plantas (Plant growth promoting rhizobacteria, PGPR). Las PGPR a menudo incrementan la superficie de raíz, con el consecuente aumento de la absorción de nutrientes y la producción de la planta. (Bashan et al., 1996; Kloepper, 2003; Bhatacharyya y Jha, 2012). Ensayos realizados con diversas PGPR en diferentes suelos, regiones climáticas y cultivos de importancia agronómica demostraron 5 – 30 % de incremento en el rendimiento, así como, la disminución de 25 – 50 % de la dosis del fertilizante químico (Aguado y Moreno, 2008; Adesemoye et al., 2009; García et al., 2012); sin embargo, también se han reportado resultados contradictorios en los que no se ha obtenido la respuesta positiva esperada, posiblemente porque los microorganismos no se adaptaron a las condiciones del suelo, muy diferentes a las de su procedencia, no compitieron exitosamente con la biota nativa o no fueron capaces de sobrevivir en condiciones desfavorables (Díaz et al., 2001). El desarrollo de una gran variedad de malezas en cultivos de maíz en la región de Lambayeque, sería posible aislar e identificar especies de Azotobacter spp. que posean características y propiedades como promotoras del crecimiento de plantas; sin embargo, en la actualidad no se han realizado estudios para aislarlas, caracterizarlas y posteriormente determinar su efecto en los cultivos agrícolas. Por lo expuesto, se planteó la siguiente investigación, teniendo como objetivos, identificar malezas en cultivos de maíz en los distritos de Monsefú y Reque, Departamento de Lambayeque, aislar e identificar especies de Azotobacter spp. de la rizósfera de las malezas; determinar in vitro el potencial biológico de Azotobacter spp. como productores de enzimas y ácido indolacético, fijadoras de nitrógeno, solubilizadoras de fósforo, antagonistas de Fusarium verticilliodes, determinar el efecto en la emergencia y sobrevivencia de plántulas de maíz amarillo duro híbrido simple inoculado con Azotobacter spp. en condiciones de invernadero.
2. Materiales y Métodos
Diseño Metodológico
Se utilizó el diseño transeccional descriptivo según Hernández et al. (2003) para indagar la incidencia y los valores que manifestaron las variables dentro de un enfoque cuantitativo, permitiendo medir las propiedades de las variables y proporcionar su descripción; en la investigación las variables cuantitativas fueron los cultivos puros de Azotobacter spp. productores de enzimas, ácido indol acético, fijadoras de nitrógeno, solubiliza-doras de fósforo y antagonistas del hongo Fusarium verticillioides. El trabajo de investigación se ejecutó en dos fases. En la primera fase, se realizó la identificación de malezas para luego realizar el aislamiento, detección, selección de Azotobacter spp. y determinar su potencial como promotor de crecimiento vegetal, realizado en el Laboratorio de Biotecnología de la Facultad de Ciencias Biológicas de la Universidad Nacional “Pedro Ruiz Gallo”. La segunda fase, se determinó el porcentaje de emergencia y sobrevivencia en plántulas de maíz inoculadas con Azotobacter ssp. en el invernadero de la Facultad de Ciencias Biológicas.
Muestreo
Se colectaron 54 muestras de malezas junto con su suelo rizosférico en 17 campos comerciales de maíz de los distritos de Monsefú y Reque, Región Lambayeque, determinando la posición de cada punto de muestreo con un GPS GARMIN e Trex Vista HCx (Tabla 1).
El distrito de Monsefú abarca 44,94 km2 y está comprendido entre los paralelos 6º 52’30” latitud sur y 79º 52’09” longitud oeste, con un clima desértico subtropical árido y un rango de temperatura de 15,37 - 28,27 ºC. A su vez, el distrito de Reque tiene una superficie de 47,03 km2 y se ubica entre los paralelos 6°52’00” latitud sur y 79°49’27” longitud oeste, presentando un clima seco tropical, cuya temperatura oscila entre 19 y 22 ºC, llegando hasta los 33 ºC en verano (Municipalidad Distrital de Monsefú, 2013; Municipalidad Distrital de Reque, 2013). Las muestras se transportaron al Laboratorio de Microbiología y Parasitología sección de Biotecnología Microbiana de la facultad de Ciencias Biológicas en la Universidad Nacional Pedro Ruiz Gallo, Perú.
Aislamiento de Azotobacter spp.
Para el aislamiento de las bacterias fijadoras de nitrógeno de suelo rizosférico se utilizó la metodología del “enriquecimiento” descrita por Escobar y Horna (2011) y modificada por los autores. Cada muestra de suelo rizosférico fue deshidratada bajo sombra durante 72 horas y después fue triturada y tamizada. Del material obtenido se tomaron 10 g para realizar una dilución en 90 mL de solución salina esterilizada: NaCl 0,87 %, p/v y dos diluciones decimales (10-2 y 10-3) en caldo Ashby sacarosa con indicador azul de bromotimol 0,5 %. Las diluciones 10-2 y 10-3 se incubaron a 30 oC, por 4 días y se consideraron positivas al enriquecimiento, aquellas donde se observó viraje del verde al amarillo, turbidez y una película superficial en el caldo. Posteriormente, para el aislamiento, se tomó una alícuota de cada tubo positivo, se sembró mediante la técnica francesa en placas de Petri con agar Ashby sacarosa y se incubó a 30 oC, hasta por 5 días, realizándose la primera lectura a las 48 horas. Una vez desarrolladas las colonias en agar Ashby sacarosa, se seleccionaron las grandes, brillantes, no translúcidas y con bordes irregulares y se obtuvo una asada de cada colonia para realizar una suspensión celular en 1 mL de solución salina esterilizada. A continuación, se tomó una alícuota de la suspensión, se sembró mediante la técnica de agotamiento y estría en agar Mineral sin nitrógeno, Nfb y se incubó a 30 oC por 48 horas. Con las colonias desarrolladas se realizó tinción de Gram y cuando se observaron bacilos grandes, gruesos, Gram negativos y formas quísticas se seleccionaron y se sembraron en agar tripticasa a 30 oC por 48 horas, constituyendo los cultivos puros que guardaron en refrigeración (8 oC).
Para la identificación del género y especies de Azotobacter según Brenner et al. (2005) se realizaron las pruebas de catalasa, reducción de nitratos, utilización de sacarosa, glucosa, maltosa, manitol, ramnosa, glicerol y sorbitol.
Producción de enzimas
Los cultivos puros de Azotobacter spp. fueron sembrados por puntura superficial con asa bacteriológica en anillo (0,4 cm de diámetro) sobre agar leche 1 % y agar quitina coloidal al 1 % y fueron incubadas a 30 °C, por 48 y 120 horas, respectiva-mente, en aerobiosis, para la investigación de la actividad proteolítica (Rios y Zuñiga, 2012) y quitinolítica (Franco, 2008). Con este propósito se observaron las colonias desarrolladas para detectar y medir el halo de hidrólisis o zona clara alrededor que evidenció la actividad proteolítica. A su vez, las bacterias que desarrollaron en agar quitina se consideraron con actividad quitinolítica.
Detección y cuantificación de ácido indol acético (AIA) producido in vitro
Para la detección y cuantificación de ácido indolacético según la reacción colorimé-trica de Salkowski descrita por Mantilla (2007), García y Muñoz (2010), cada cultivo puro de Azotobacter spp. fueron cultivados en 5 mL de caldo nutritivo por 24 horas, de donde se tomaron 0,6 mL para inocularlos en 5 mL de caldo tripticasa soya suplementado con triptófano. Después de la incubación a 30 ºC, por 72 horas, en agitación constante (150 rpm), los cultivos fueron centrifugados a 3000 rpm, durante 5 minutos. A continuación 0,4 mL de cada uno de los sobrenadantes se depositaron en tubos, se agregaron 1,6 mL del reactivo de Salkowski modificado en una relación 1:4, se mezclaron y se dejaron en reposo durante 30 minutos, en oscuridad. La positividad a la producción de ácido indolacético estuvo dada por una coloración grosella y se leyó la absorbancia en espectrofotómetro de luz visible a 530 nm. Las concentraciones se calcularon en una recta patrón que fue obtenida con diluciones sucesivas de una solución 100 ppm de ácido indolacético.
Detección y cuantificación de nitrógeno fijado in vitro
Para la detección de nitrógeno fijado in vitro según Cadena y Martínez (2011), cada cultivo puro de Azotobacter spp. fue sembrado por puntura en 6 mL de medio semisólido libre de nitrógeno con azul de bromotimol (Nfb). La incubación se realizó en aerobiosis, a 30 ºC, hasta por 1 semana y se consideraron como bacterias fijadoras de nitrógeno, aquellas donde se observó una película gruesa blanquecina 3 – 5 mm bajo la superficie del medio de cultivo y el viraje del indicador. Para la cuantificación de nitrógeno fijado in vitro se utilizó el método colorimétrico del fenolhipoclorito, descrito por Lara et al. (2007), Cadena y Martínez (2011). Cada una de las bacterias nativas cultivadas en agar nutritivo por 24 horas, fueron inoculadas en tubos de 15 x 150 mL conteniendo 3 mL de caldo extracto de suelo y se incubaron a 30 °C, por 72 horas en agitación constante (150 rpm). A continuación, se agregaron 9 mL de KCl 2M, se agitaron a 150 rpm, durante 1 hora y se dejaron en reposo por 1 hora adicional, para después tomar 10 mL del sobrenadante y centrifugarlos (3000 rpm) durante 5 minutos. Luego, los sobrenadantes se vertieron en tubos de dilución, se añadieron 0,4 mL de solución alcohólica de fenol al 10 %; 0,4 mL de nitroprusiato de sodio al 0,5 % y 1 mL de solución oxidante. Se agitaron para mezclar y después se dejaron en reposo durante 1 hora. La positividad a la fijación del nitrógeno in vitro estuvo dada por una coloración azul y se leyó la absorbancia en espectrofotómetro de luz visible, a 632,9 nm. Las concentraciones de nitrógeno fijado como amonio, se calcularon en una recta patrón que fue obtenida con diluciones sucesivas de una solución de 100 ppm de cloruro de amonio.
Detección y cuantificación de fósforo solubilizado in vitro
Para la detección de fósforo solubilizado in vitro, se utilizó la metodología descrita por Vázquez et al. (2000). Cada cultivo puro de Azotobacter spp. fueron sembrados por puntura superficial en agar para aislamiento de microorganismos solubilizadores de fósforo, Sundara Rao Sinha Medium, SRSM. Las placas de Petri se incubaron a 30 ºC, por 96 horas y las colonias solubilizadoras de fósforo fueron reconocidas por el cambio de color del indicador al amarillo y la formación de un halo traslúcido alrededor de la colonia. Después, las colonias se cultivaron nuevamente en agar SRSM, para verificar la actividad solubilizadora de fósforo y se determinó el diámetro del halo formado alrededor de las colonias que conservaron su capacidad para solubilizar fósforo. Para la cuantificación del fósforo solubilizado, se obtuvo el inóculo de cada una de las bacterias solubilizadoras de fósforo cultivadas en 1 mL de caldo SRSM a 30 ºC, durante 20 horas en agitación constante a 150 rpm. A continuación; 0,6 mL de cada uno de los cultivos de Azotobacter spp. fueron inoculados en tubos con 6 mL de caldo SRSM e incubados a 30 ºC, con agitación constante (150 rpm). Después de 72 horas los caldos SRSM fueron centrifugados a 3000 rpm por 5 minutos y en el sobrenadante se cuantificó el fósforo soluble mediante el método colorimétrico del molibdato según Rodier y Rodi (2005). Los resultados se expresaron como fósforo solubilizado (ppm).
Prueba de antagonismo
Para la prueba de antagonismo se utilizó la técnica de enfrentamiento en “cultivo dual” descrita por Fernández y Vega (2001), según la cual cada cultivo puro de Azotobacter spp. se sembró masivamente en uno de los cuatro extremos de una placa de petri con agar papa dextrosa (PDA), ocupando aproximadamente un cuarto del área total y se incubó a 30 ºC, por 72 horas. A continuación, un fragmento (0,9 cm de diámetro) del hongo F. verticillioides se depositó en el centro de las placas de petri a una distancia de 3 cm respecto a Azotobacter spp. Después de 5 días de incubación a 30 °C, se midió el radio de la colonia del hongo y de la placa testigo. Para determinar si el crecimiento fúngico fue afectado por enterobacterias se aplicó la formula citada por Fernández y Vega (2001):
% inhibición= ((RT-R2) / RT) ×100
Donde RT = Radio del testigo de F. verticilloides sembrado en PDA; R2 = Radio de la colonia de F. verticilloides sembrado en PDA con Azotobacter spp. nativas.
Los resultados se expresaron con porcentaje de inhibición del crecimiento respecto al testigo.
Determinación de la emergencia y sobrevivencia de maíz
Para determinar la emergencia de plántulas de maíz amarillo hibrido simple, se inoculó independientemente cada uno de los 100 cultivos puros de Azotobacter spp. en 500 semillas de maíz, distribuidas en grupos de cinco. Diariamente, hasta 7 días después de la inoculación de los cultivos puros de Azotobacter spp. en las semillas de maíz se contaron las plántulas emergidas, calculándose posteriormente el porcentaje de emergencia. Se calculó el porcentaje de emergencia a través de la comparación de semillas inoculadas con cultivos puros de Azotobacter spp. y semillas inoculadas con agua destilada.
La determinación de sobrevivencia de plántulas de maíz, se realizó mediante la inoculación de cada uno de los 100 cultivos puros de Azotobacter spp. en la risosfera de las plántulas. Se contaron las plántulas sobrevivientes hasta 20 días después de la inoculación de los cultivos puros de Azotobacter spp. en la rizósfera, calculándose posteriormente el porcentaje de sobrevivencia. Se calculó el porcentaje de sobrevivencia mediante la comparación de plántulas inoculadas con cultivos puros de Azotobacter spp. en la risosfera y testigo de plántulas inoculadas con agua destilada en la rizósfera.
3. Resultados y discusión
Malezas identificadas en el cultivo de Zea mays L. “maíz” en Lambayeque
En el presente estudio se identificaron 16 especies de malezas (Tabla 2). Las cuales fueron reportadas en diversas investigaciones, para el aislamiento rizobacterias promotoras de crecimiento vegetal, mencionándose entre las monocotiledóneas a S. halepense, E. colona, C. dactylon, L. filiformis (Gonzáles, 2001; Castro, et al., 2004; García y Mejía, 2005; Delgado, 2011), E. pacifica (Tovar, 2005), S. verticillata, S. parviflora (Delgado, 2011), C. rotundus (García y Mejía, 2005; Idrogo, 2005; Delgado, 2011), Ch. virgata, Ch. álbum, O. latifolia, Ch. gayana (Delgado, 2011).
A su vez, entre las dicotiledóneas se han reportado Amarantus spp., E. heterophylla (Castro, 2006; Delgado, 2011), C. incana (Planchuelo y Carreras, 2011), B. pilosa (Castro, 2006), M. coromandelianum (Castro, 2006; Delgado, 2011), B. erecta, D. virgatus (Lira y Blanckaert, 2006; Zabala et al., 2010), Ch. hypercifolia (Hernández et al., 2003; Lira y Blanckaert, 2006), D. tortuosum, M. lathyroides (Menéndez et al., 1996), L. mollis (Najul y Anzalone, 2006), M. quinquefolia (Golden Environmental Corporation, 2008), N. physalodes (Sotomayor y Jiménez, 2008), P. oleracea, P. philadelphica, S. oleraceus, Ch. murale, L. virginicum, T. portulacastrum (Delgado, 2011), Solanum spp. (Zelada, 2004; Delgado, 2011), S. spinosa (Chávez y Guevara, 2003; Tovar, 2005) y P. foetida (Ocampo, 2007).
Especies de Azotobacter spp. aisladas e identificadas
El 100% de muestras rizosféricas de malezas asociadas a maíz fue positivo en el enriquecimiento para bacterias fijadoras de nitrógeno de suelo, siendo reconocidas por el viraje del indicador al amarillo, una película superficial y turbidez, coincidiendo con Orozco y Martínez (2009) y Salhia (2010). Las bacterias diazótrofas como Azotobacter spp. producen ácidos orgánicos, que disminuyen hasta 4,8 el pH del medio en el que desarrollan, con viraje del indicador azul de bromotimol (Espín, 2008). Estas bacterias son aerobias y desarrollan en la superficie de los medios de cultivo; no obstante, tienen flagelos que les permiten movilizarse y distribuirse en todo el medio, observándose después de 24 horas una turbidez característica (Escobar y Horna, 2011; Obando, 2012).
Para aislar Azotobacter spp. y descartar los contaminantes se realizaron aislamientos en agar Ashby sacarosa y subcultivos en agar Nfb libre de nitrógeno, coincidiendo con Rico (2009). A su vez, 43,7 % de las bacterias fijadoras de nitrógeno aisladas de rizósfera de malezas, se identificaron como Azotobacter spp., superando 38,81% reportado por Escobar y Horna (2011) en rizósfera de hortalizas en Lambayeque. Azotobacter spp. también ha sido identificado en rizósfera de la maleza Chrysopogon aucheri, así como también en maíz (Hernández et al., 2003; Salhia, 2010).
Entre los cultivos de Azotobacter spp. nativas se identificaron cuatro especies (Tabla 3) correspondientes a A. vinelandii (58 %), A. paspali (13 %), A. armeniacus (8 %), A. nigricans (8%) y en 13 cultivos no se identificó la especie. A. vinelandii se identificó en las 16 especies de malezas, A. armeniacus en siete, A. paspali en seis y A. nigricans en cinco. A su vez, las cuatro especies de Azotobacter se aislaron de Bidens pilosa y Cyperus rotundus.
Potencial biológico de enterobacterias nativas
El 18% de Azotobacter spp. nativas presentó actividad proteolítica detectada en agar leche (Figura 1), donde la caseína es la principal proteína y se presenta como una solución coloidal, responsable del color blanco y opacidad del medio. La actividad proteolítica es detectada cuando las bacterias producen la enzima caseinasa, la cual hidroliza la caseína, formándose alrededor de las colonias bacterianas halos, que son derivados solubles y cristaloides por donde atraviesa la luz y se observan zonas transparentes (Ríos y Zúñiga, 2012). A su vez, 68% de Azotobacter spp. presentó actividad quitinolítica (Figura 2), gracias a la producción de quitinasas, enzimas que hidrolizan la quitina u homopolìmero formado por residuos de N–acetil–D–glucosamina con enlaces β, 1 – 4. La actividad enzimática no es característica de Azotobacter spp. como PGPR, pero si lo es en Bacillus y actinomicetos, en los que constituye un mecanismo de control de hongos fitopatógenos (Layton et al., 2011; Tejera et al., 2011).
En el presente estudio, se cuantificó 60,75 ppm de AIA superior a 32 – 56 ppm reportados por Guineth et al. (2000), Lara et al (2007), Escobar y Horna (2011) para aislados de arroz, rastrojos y hortalizas. También se ha registrado un rango de 7,6 – 101 ppm en aislados de papa, aunque el rango promedio para Azotobacter spp. es de 3 – 65 ppm (Anwar, 2000).
El 83% de las bacterias nativas evidenció ser diazotrofo al detectarse amonio como producto de la fijación de nitrógeno en caldo extracto de suelo. De igual manera, Lara et al. (2007), Kizilkaya (2009), Escobar y Horna (2011), Obando et al. (2010) reportaron fijación de nitrógeno por estas bacterias, identificando A. vinelandii, A. chroococcum, A. agilis, A. beijerinckii, A. insignis, A. paspali y A. macrocytogenes. El amonio fue cuantificado por el método Bertholet (fenol – hipoclorito), basado en la aparición de un azul intenso de indofenol, producto de la reacción del ión amonio (NH4) con los compuestos fenólicos, en presencia del agente oxidante hipoclorito de sodio y un catalizador como el nitroprusiato de sodio o el ferrocianato de potasio (Lara et al., 2007). En el presente estudio se cuantificó hasta 36,03 ppm, superando ampliamente a 1,6 y 5,2 registrados por Escobar y Horna (2011) y Lara et al. (2007) para aislados de tomate y plátano.
El 72% de Azotobacter spp. nativas solubilizó fosfato dicálcico superando a 46,7% registrado por Rico (2009) para aislados de papa. Para evidenciar esta actividad se utilizó el agar SRSM con fosfato dicálcico como fuente de fosforo, observándose acidificación y halos de solubilizaciòn. Por el contrario, Escobar y Horna (2011) solo reportaron acidifica-ción. El 86% de las bacterias nativas presentó efecto antagónico a Fusarium verticilliodies evidenciado a través de la inhibición del crecimiento micelial (Tabla 4, Figura 3) con la técnica del enfrentamiento, alcanzando 21,87 % inferior a 42,3 % reportado por Rico (2009) para la inhibición de Fusarium solani por aislados de papa.
Efecto de Azotobacter spp. nativas en la emergencia y sobrevivencia en plántulas de maíz amarillo duro
Las bacterias nativas afectaron diferencialmente la emergencia de las plántulas de maíz a los 7 días (Figura 4), observándose incremento, disminución o ningún efecto en comparación con el testigo. El 33% de las rizobacterias nativas incrementó la emergencia de maíz, valor similar a 34% reportado por Casos y Santiago (2013) para Azospirillum spp. aisladas de malezas, el incremento en el vigor de las plántulas se asocia con la síntesis de auxinas (Nezarat y Gholami, 2009).
El 47% de las bacterias nativas disminuyó la emergencia, valor inferior a 56% reportado con Azospirillum spp. aisladas de malezas. Este efecto negativo también fue observado por Di Barbaro et al. (2005) con 16,6% – 18,7% de emergencia en las semillas de Capsicum annum L. “pimienton pimientonero” inoculadas con Azospirillum brasilense, frente a 19,3% en el testigo al día 7. Los resultados son explicados por desbalances en la síntesis de enzimas, debido a la competencia por nutrientes entre las semillas y las bacterias inoculadas (Stefan et al., 2008) y metabo-litos volátiles que pueden afectar positiva y negativamente la emergencia y desarrollo vegetativo de las plántulas (Rico, 20009).
4. Conclusiones
Se identificaron 16 especies de malezas en los cultivos de maíz en los distritos de Monsefú y Reque en Lambayeque. De las muestras de suelo rizosférico obtenidas de las malezas identificadas en los cultivos de maíz, se aislaron e identificaron cuatro especies de Azotobacter spp. Correspondientes a A. vinelandii (58 %), A. paspali (13 %), A. armeniacus (8 %), A. nigricans (8 %). En 13 cultivos de Azotobacter no se identificó la especie. Se determinó el potencial biológico in vitro de las especies de Azotobacter spp cuantificándose 2,25 - 60,75 ppm de ácido indolacético; 10,37 - 36,03 ppm de nitrógeno fijado como amonio y 1,72 - 6,06 ppm de fósforo solubilizado; se detectó actividad proteolítica en 18% de los cultivos puros de Azotobacter spp, quitinolítica en 68% de los cultivos puros y 86% de los cultivos puros presentaron una actividad antagónica frente a Fusarium verticillioides. Se determinó la emergencia de las plántulas de maíz amarillo duro hibrido simple con 33% de Azotobacter spp. nativas incrementando la emergencia; 20% sin afectarla y 47% disminuyéndola. Ningún cultivo de puro de Azotobacter spp. afectó la sobre-vivencia de las plántulas de maíz a los 20 días de la inoculación, alcanzando 100% en todas las plántulas.
5. Referencias bibliográficas
Adesemoye, A.; Torbert, H.; Kloepper, J. 2009. Plant growth-promoting rhizobacteria allow reduced application rates of chemical fertilizers. Microbial Ecology 58: 921-929. [ Links ]
Aguado, A.; Moreno, B. 2008. Biofertilizantes bacterianos desarrollados por INIFAP. En Aguado A. Introducción al uso y manejo de fertilizantes en agricultura. INIFAP 2(1): 151-170.
Anwar, G. 2000. Production of growth hormones and nitrogenase by diazotrophic bacteria and their effect on plant growth. Tesis de Doctorado. University of Punjab, Lahore, India. [ Links ]
Bashan, Y.; Holguin, G.; Ferrera, R. 1996. Interacciones entre plantas y microorganismos benéficos. Terra 14(2): 159-194. [ Links ]
Cadena, S.; Martínez, B. 2011. Caracterización de cepas de Pseudomonas spp. y su efecto en la germinación y emergencia de Zea mays L. “maíz” en Lambayeque. Tesis de Licenciatura. Universidad Nacional Pedro Ruiz Gallo, Lambayeque, Perú [ Links ].
Casos, I.; Santiago, P. 2013. Potencial promotor del crecimiento de plantas de las especies de Azospirillum aisladas de raíces de malezas asociadas a Zea mays L. “maíz” en Lambayeque, 2013. Tesis de Licenciatura. Universidad Nacional Pedro Ruiz Gallo, Lambayeque, Perú [ Links ].
Castro, J.; Portillo, J.; Bojórquez, G.; Cruz, J.; Godoy, T.; Gastelum, R. 2004. Colecta e identificación de malezas presentes en cultivos hortícolas y granos básicos en los valles de culiacán, navolato, guasave y la cruz de elota, sinaloa. Cuerpo Académico de Fitoprotección. Facultad de Agronomía, Universidad Autónoma de Sinaloa, México. [ Links ]
Castro, M. 2006. Efecto de la fertilización organica en el cultivo de maíz (Zea mays L.) en el distrito de Santo Domingo de la Capilla, provincia de Cutervo, región Cajamarca. Tesis Ingenieria. Universidad Nacional Pedro Ruiz Gallo, Lambayeque, Perú [ Links ].
Chávez, A.; Guevara, F. 2003. Flora arvense asociada al cultivo de maíz de temporal en el valle de Morelia, Michoacan, México. Flora del Bajío y de regiones adyacentes. México: Universidad Michoacana de San Nicolás de Hidalgo. Disponible en: http://www1.inecol.edu.mx/publicaciones/resumeness/FLOBA/ComplementarioXIX.pdf. [ Links ]
Delgado, Y. 2011. Control de malezas en cultivo de maíz (Zea mays L.) utilizando tres herbicidas pre-emergentes, en la granja “La Pradera” Chaltura – Imbabura. Universidad Técnica Del Norte, Ecuador. [ Links ]
Díaz, P.; Dávila, J.; Espinosa, M.; Cárdenas, H. 2001. Inoculación de bacterias promotoras del crecimiento en lechuga. Terra (19): 327 – 335. [ Links ]
Di Barbaro, G.; Pernasetti, S.; Stegmayer, A. 2005. Evaluación del efecto de Azospirillum brasilensis en la germinación y emergencia del pimiento pimentonero (Capsicum annuum L. var trompa de elefante). Revista del CIZAS 6 (12): 74 – 85. [ Links ]
Escobar, C.; Horna, Y. 2011. Caracterización de cepas nativas de Azotobacter spp. y su potencial como promotoras del desarrollo vegetativo de “tomate” (Lycopersicon esculentum Mill.). Tesis de Licenciatura. Universidad Nacional Pedro Ruiz Gallo, Lambayeque. [ Links ]
Espín, G. 2008. Biología de Azotobacter vinelandii. Instituto de Biotecnología, Universidad Nacional Autónoma de México. Disponible en: http://www.microbiologia.org.mx/microbiosenlinea/CAPITULO_09/Capitulo09.pdf [ Links ]
Franco, M. 2008. Evaluación de caracteres PGPR en Actinomicetos e Interacciones de esta Rizobacterias con hongos Formadores de Micorrizas. Tesis doctoral. Universidad de Granada, España. [ Links ]
Fernández, O.; Vega, L. 2001. Microorganismos antagonistas para el control fitosanitario. Manejo Integral de Plagas 62: 96- 100. [ Links ]
García, P.; Mejía, M. 2005. Control químico de las malezas en maíz en un sistema de siembra directa. Revista Agronomía Tropical 55(3): 363 - 380. [ Links ]
García, J.; Mendoza, A.; Mayek, N. 2012. Efecto de Azospirillum brasilense en el rendimiento del maíz en el norte de Tamaulipas, México. Universidad y Ciencia 28(1): 79-84. [ Links ]
García, F.; Muñoz, H. 2010. Caracterización de cepas nativas de Azospirillum spp. y su efecto como promotor del desarrollo vegetativo de arroz (Oryza sativa). Tesis de Licenciatura. Universidad Nacional Pedro Ruiz Gallo, Lambayeque, Perú [ Links ].
Golden Environmental Corporation. 2008. Estudio de Flora y Fauna: Desarrollo Residencial. Barrio Espinosa, Vega Alta, Puerto Rico. [ Links ]
Gonzáles, J. 2001. Efectos de la fertilización N-P-K en el rendimiento y calidad de choclo en la parte baja del valle Chancay. Tesis de Ingeniería. Universidad Nacional Pedro Ruiz Gallo, Lambayeque, Perú [ Links ].
Guineth, T.; Valencia, S.; Bernal, J.; Martinez, P. 2000. Isolation of enterobacteria, Azotobacter sp. and Pseudomonas sp, producers of indolle-3-acetic acid and siderophores, from Colombia rice rhizosphere. Revista Lationamericana de Microbiología 42: 171 -176. [ Links ]
Hernández, R.; Fernández, C.; Baptista, P. 2003. Metodología de la Investigación. México: Mc Graw Hill Interamericana Editores S.A. [ Links ]
Hernández, A.; Caballero, A.; Pazos, M.; Ramírez, R.; Heydrich, M. 2003. Identificación de algunos géneros microbianos asociados al cultivo de maíz (Zea mays L.) en diferentes suelos de Cuba. Revista Colombiana de Biotecnología 5(1): 45-55. [ Links ]
Injante, P.; Joyo, G. 2010. Curso-Taller: Manejo integrado de maíz amarillo duro. Universidad Nacional Agraria La Molina. La Libertad, Perú [ Links ].
Kloepper, J. 2003. A review of mechanisms for plant growth promotion by PGPR. 6th Internacional PGPR workshop. 6-10 october. Calicut, India. [ Links ]
Kizilkaya, R. 2009. Nitrogen fixation capacity of Azotobacter spp. strains isolated soils in different ecosystems and relationship between them and the microbiological properties of soils. Journal of Environmental Biology 30(1): 73 – 82. [ Links ]
Lara, C.; Villalba, M.; Oviedo, L. 2007. Bacterias fijadoras asimbióticas de nitrógeno en la zona agrícola de San Carlos. Revista Colombiana de Biotecnología 9(2): 6-14. [ Links ]
Layton, C.; Maldonado, E.; Monroy, L.; Corrales, L.; Sánchez, L. 2011. Bacillus spp.; perspectiva de su efecto biocontrolador mediante antibiosis en cultivos afectados por fitopatógenos. Disponible en: http://www.unicolmayor.edu.co/invest nova/NOVA/NOV16 ARTREVIS1 BACILLUS.PDF. [ Links ]
Lira, R.; Blanckaert, I. 2006. Estudio etnobotánico de las malezas útiles presentes en difetentes agroecosistemas en el municipio de Santa Maria Tecomavaca, Valle de Tehuacán – Cuicatlán, Mexico: Universidad Nacional Autonoma de Mexico. Disponible en: http://www.conabio.gob.mx/institucion/proyectos/resultados/InfBE010.pdf. [ Links ]
Mantilla, M. 2007. Evaluación de la acción de un bioinoculante sobre un cultivo de crisantemo (Chrysanthemun morifolium var. yoko ono) en periodo de enraizamiento. Tesis Microbiólogo Agrícola Veterinario. Pontificia Universidad Javeriana, Bogotá, Colombia. [ Links ]
Menéndez, J.; Matheu, J.; Vasallo, A.; Tang, M.; Roche, R. 1996. Biogeografía de leguminosas forrajeras en Cuba. I. Provincia de Matanzas. Pastos y Forrajes 19(1): 15 – 32. [ Links ]
Municipalidad Distrital de Monsefú. 2013. Disponible en: http://munimonsefu.gob.pe/
Municipalidad Distrital de Reque. 2013. Disponible en. http://www.peru.gob.pe/Nuevo_Portal_Municipal/portales/Municipalidades/1244/entidad/pm_municipalidad.asp
Najul, C; Anzalone, A. 2006. Control de malezas con cobertura vegetal en el cultivo de la Caraota negra (Phaseolus vulgaris L.). Bioagro 18(2): 75 - 82. [ Links ]
Naz, L.; Bano, A.; Rechman, B.; Pervaiz, S.; Iqbal, M.; Sarwar, A.; Yasmin, F. 2012. Potencial of Azotobacter vinelandii Khsrl as bio-inoculant. African Journal of Biotechnology 11(45): 10368 – 10372. [ Links ]
Nezarat, S.; Gholami, A. 2009. Screening Plant Growth Promoting Rhizobacteria for improving germination seedling growth and yield of maize. Pakistan Jounal of Biological Sciences 12(1): 26 – 32. [ Links ]
Obando, D.; Burgos, L.; Rivera, D.; Rubiano, M.; Divan, V.; Bonilla, R. 2010. Caracterización de bacterias diazotróficas asimbióticas asociadas al eucalipto (Eucayptus sp.) en Codazzi, Cesar (Colombia). Acta Biología Colombiana 15(3): 107 - 120. [ Links ]
Ocampo, J. 2007. Diversity of Colombian Passifloraceae: biogeography and an updated list for conservation. Biota Colombiana 8(1): 1 – 45. [ Links ]
Orozco, C.; Martínez, P. 2009. Evaluación de la inoculación con microorganismos fijadores de nitrógeno simbióticos aislados de la rizósfera de Pinus patula en Colombia. Bosque 30 (2): 70 – 77. [ Links ]
Planchuelo, A.; Carreras, M. 2011. Evaluación de la diversidad morfológica en Crotalaria incana (Fabaceae, Faboideae), una leguminosa silvestre de valor forrajero. Agriscientia 28(1): 39 – 49. [ Links ]
Rico, M. 2009. Capacidad promotora de crecimiento vegetal por bacterias del género Azotobacter y Actinomicetos aislados de cultivos de Solanum tuberosum Linnaeus, 1753 (Papa) cultivados en zonas alto andinas del Perú. Tesis de Biología. Universidad Nacional Mayor de San Marcos, Lima, Perú [ Links ].
Ríos, P.; Zúñiga, L. 2012. Bacillus spp. aisladas de rizósfera de Lycopersicon esculentum Mill. “tomate” en Lambayeque y su potencial coimo promotoras del crecimiento de plantas. Tesis de Licenciatura. Universidad Nacional Pedro Ruiz Gallo, Lambayeque, Perú [ Links ].
Rodier, J.; Rodi, L. 2005. Análisis de Aguas. Control de Calidad del Agua Editorial Omega. Barcelona, España. [ Links ]
Tejera, B.; Rojas, M.; Heydric, M. 2011. Potencialidades del género Bacillus en la promoción del crecimiento vegetal y el control biológico de hongos fitopatógenos. Revista CENIC Ciencias Biológicas 42(3): 131 – 138. [ Links ]
Tovar, O. 2005. Estudio florístico de los pastizales de las Costa Norte del Perú. Revista Peruana Biología 12(3): 397 – 413. [ Links ]
Salhia, B. 2010. The effect of Azotobacter chroococcum as nitrogen biofertilizer on the growth and yield of Cucumis sativus. Degree of Master. The Islamic University – Gaza. [ Links ]
Sotomayor, A.; Jiménez, P. 2008. Patrones de Sucesión Vegetal: Implicancias para la conservación de las Lomas de Atiquipa del Desierto Costero del Sur del Perú. Zonas Áridas 12(1): 74 – 96. [ Links ]
Stefan, M.; Mihasan, M.; Dunca, S. 2008. Plant growth promoting rhizobacteria can inhibit the in vitro germination of Glycine max L. seeds. Annals of the University Alexandru Ioan Cuza. Genetics and Molecular. Biology Section 9(3): 105 – 110. [ Links ]
Vázquez, P.; Holguin, G.; Puente, M., López, A.; Bashan, Y. 2000. Phosphate solubilizing microorganisms associated with the rhizosphere of mangroves in a semiarid coastal lagoon. Biology and Fertility of Soils 30(1): 400-408. [ Links ]
Zabala, J.; Giavedoni, J.; Tomas, P.; Budini, E. 2010. Variabilidad en caracteres morfológicos relacionados con la implantación de Desmanthus virgatus (L) Willd y D. paspalaceus (Lindm) Burkart. Agriscientia 27(2): 95 - 105. [ Links ]
Zelada, A. 2004. Comparativo de la adaptabilidad de 12 híbridos tropicales de maíz amarillo duro (Zea mays L.) de calidad proteica (QPM), en la parte media del valle Chancay. Tesis de Ingeniería. Universidad Nacional Pedro Ruiz Gallo. Lambayeque, Perú [ Links ].
* Autor para correspondência
E-mail: leonmendoza9@gmail.com (L. León).
Recibido 10 agosto 2015
Aceptado 09 octubre 2015